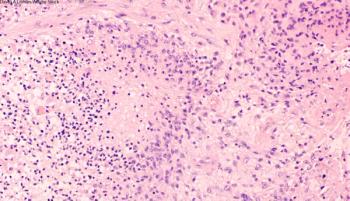

Researchers tried using deep machine learning to anticipate disease outcomes and progression in patients with lung cancer.

Your AI-Trained Oncology Knowledge Connection!


Researchers tried using deep machine learning to anticipate disease outcomes and progression in patients with lung cancer.


The phase II study compared single-agent anti-EGFR panitumumab to panitumumab combined with fluorouracil-leucovorin in patients with RAS wild-type metastatic colorectal cancer.

Researchers examined the rate and risk of late-onset anorectal disease among childhood cancer survivors.

Researchers looked at diagnosis, assessment, treatment, and prognosis of women diagnosed with cervical cancer while pregnant.

This new study looked at chronic pain rates among cancer survivors, including which survivors report the highest prevalence of pain.

A survey of oncologists found child care is a significant concern of women in the field and can greatly impact their conference attendance compared to their male counterparts.

A new study offers hope in predicting glioblastoma responses to chemotherapy, radiation, and combination therapy.

The risk of multiple primary cancers is increasing due to increasing numbers of survivors, long-term side effects of chemotherapy and/or radiation therapy, increased diagnostic sensitivity, and persisting effects of genetic and behavioral risk factors.

Researchers looked at whether or not a two-dose recombinant zoster vaccine would reduce the incidence of herpes zoster in patients with hematologic malignancies after autologous stem cell transplantation.

A new study estimated that cancer deaths in 2015 resulted in billions in lost earnings in the United States.

This study adds to the evidence that the decline in access to local care due to the shuttering of rural hospitals and community cancer clinics adversely affects cancer patients.

The FDA approved selinexor in combination with the corticosteroid dexamethasone for the treatment of adult patients with relapsed/refractory multiple myeloma.

Healthy eating, exercise, and avoiding smoking can save lives. So why aren't more doctors talking to patients about lifestyle changes?

The FDA approved daratumumab in combination with lenalidomide and dexamethasone for patients with newly diagnosed multiple myeloma who are ineligible for autologous stem cell transplant.

A new trial investigated the efficacy of XELOX vs GEMOX as first-line therapy for advanced biliary tract cancers.

Many patients complain of "chemo brain," or a drop in cognitive function during or after receiving chemotherapy, but there are strategies to manage chemo brain, as well as research on how chemotherapy affects the brain long-term.

This article reviews the prevalence of suicide in patients with cancer, risk factors, related conditions, and interventions to identify and treat suicidal patients.

The FDA approved pembrolizumab as a treatment option for patients with metastatic small-cell lung cancer.

The FDA approved pembrolizumab for the first-line treatment of patients with metastatic or unresectable recurrent head and neck squamous cell carcinoma.

The FDA granted accelerated approval to polatuzumab vedotin-piiq, a CD79b-directed antibody-drug conjugate, in combination with bendamustine and a rituximab product for adult patients with relapsed or refractory diffuse large B-cell lymphoma.

In this video, Dr. McFarland of Memorial Sloan-Kettering Cancer Center spoke with Cancer Network at ASCO 2019 about depression in lung cancer and dopamine as potential therapy.

Researchers are reporting that previous racial disparities in timely cancer treatment between African American and white patients practically disappeared in states where Medicaid access was expanded under the ACA.

This slideshow reviews the latest clinical updates surrounding the management of treatment-associated nausea and vomiting, including recommendations, newly approved agents, and more.

A worldwide crowd innovation contest incentivized international programmers to create automated AI algorithms for an area of radiation oncology.

The findings further validate the initial 2015 findings that a five-fraction SBRT schedule is appropriate for patients with centrally located NSCLC.

The percentage of patients with cancer eligible to receive immune checkpoint inhibitors has increased in recent years, but how many patients are actually responding?

Cancer Network spoke with Dr. Scarlett Lin Gomez about the role gender, socioeconomic status, race/ethnicity, and neighborhood characteristics have on health outcomes in cancer.